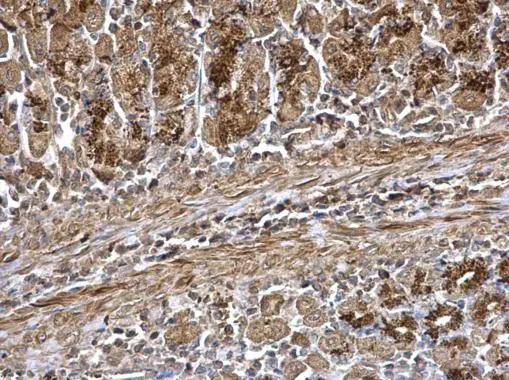
WNT7A antibody detects WNT7A protein at secreted on mouse stomach by immunohistochemical analysis. Sample: Paraffin-embedded mouse stomach. WNT7A antibody (GTX105680) dilution: 1:500. 
 Antigen Retrieval: Trilogy? (EDTA based, pH 8.0) buffer, 15min

WNT7A antibody detects WNT7A protein at secreted on mouse pancreas by immunohistochemical analysis. Sample: Paraffin-embedded mouse pancreas. WNT7A antibody (GTX105680) dilution: 1:500.
Antigen Retrieval: Trilogy? (EDTA based, pH 8.0) buffer, 15min
Wnt7a antibody
GTX105680
ApplicationsWestern Blot, ImmunoHistoChemistry, ImmunoHistoChemistry Paraffin
Product group Antibodies
ReactivityHuman, Mouse
TargetWNT7A
Overview
- SupplierGeneTex
- Product NameWnt7a antibody
- Delivery Days Customer9
- Application Supplier NoteWB: 1:1000-1:10000. IHC-P: 1:100-1:1000. *Optimal dilutions/concentrations should be determined by the researcher.Not tested in other applications.
- ApplicationsWestern Blot, ImmunoHistoChemistry, ImmunoHistoChemistry Paraffin
- CertificationResearch Use Only
- ClonalityPolyclonal
- Concentration0.21 mg/ml
- ConjugateUnconjugated
- Gene ID7476
- Target nameWNT7A
- Target descriptionWnt family member 7A
- Target synonymsSANTOS, Wnt-7a, protein Wnt-7a, proto-oncogene Wnt7a protein, wingless-type MMTV integration site family, member 7A
- HostRabbit
- IsotypeIgG
- Protein IDO00755
- Protein NameProtein Wnt-7a
- Scientific DescriptionThis gene is a member of the WNT gene family, which consists of structurally related genes that encode secreted signaling proteins. These proteins have been implicated in oncogenesis and in several developmental processes, including regulation of cell fate and patterning during embryogenesis. This gene is involved in the development of the anterior-posterior axis in the female reproductive tract, and also plays a critical role in uterine smooth muscle pattering and maintenance of adult uterine function. Mutations in this gene are associated with Fuhrmann and Al-Awadi/Raas-Rothschild/Schinzel phocomelia syndromes. [provided by RefSeq]
- ReactivityHuman, Mouse
- Storage Instruction-20°C or -80°C,2°C to 8°C
- UNSPSC41116161